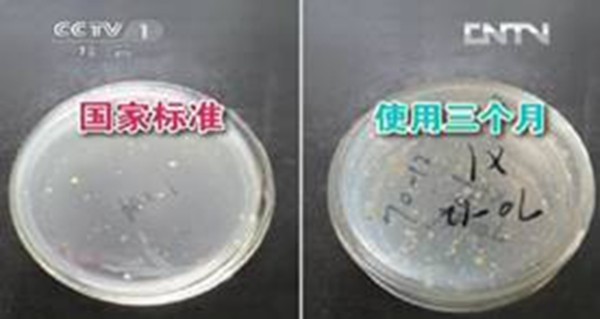

毛巾健康使用您做对了么?
使用旧毛巾做抹布,减少新毛巾购买 #生活技巧# #环保生活技巧# #环保洗涤用品#
毛巾在日常生活中使用频繁,经常与我们的面部、肌肤接触,毛巾很容易滋生细菌,所以应保持毛巾的清洁。为了您和家人的健康,更要正确的使用和洗涤毛巾。
结合中国家用纺织品行业协会的《家用纺织品消费指南》以及团体标准 T/HOMETEX4-2018《毛巾健康使用指南》,现将毛巾的使用及维护注意事项进行总结,为大家正确使用毛巾提供参考。

专人专用,专巾专用
毛巾产品是毛圈结构,蓬松稀疏,易藏污纳垢和隐匿细菌微生物等。人们在使用毛巾时,皮肤分泌物、皮屑、灰尘、环境污染物等会转移到毛巾上,造成微生物的滋生和繁殖。
在很多家庭里,一条毛巾家人共用且"身兼数职"——洗脸、擦手、洗澡、洗头等。如此一来,来自手上、脸上、头发以及毛巾使用后滋生的细菌就会布满全身且会交叉传播,如果病菌进入口鼻腔、眼睛等敏感部位,还可能会引起不适,尤其是孩子和过敏体质的人,更容易中招。因此,为了避免细菌和疾病的交叉感染,家庭成员间的毛巾不共用、不混用,做到以下两点:
专人专用:避免皮肤上的细菌通过毛巾交叉传染。
专巾专用:洗脚、洗脸、洗澡的毛巾要分开使用。

温情提示:最好将每个人的毛巾隔离放置,避免接触!
及时洗涤晾晒
认识洗涤标签
洗涤标签的常用洗涤符号如下,请正确洗涤毛巾,获得良好的消费体验。

新毛巾请洗后再用
毛巾从制造到销售到消费者手中,经过多人的触摸。购买新毛巾后,首次使用前,宜采用适当的方法进行洗涤,以去除在制造和销售过程中的污染。
使用后最好立即洗涤晾晒或烘干
使用后的毛巾在潮湿状态下,极易滋生和繁殖细菌,甚至发霉变质。而人们通常习惯把毛巾放在卫生间里,这就为细菌的滋生提供了"温床",再加上空气中灰尘、皮肤油脂、外界病菌的侵扰,会让毛巾越用越脏。长期使用后的毛巾,不但性能降低,起不到清洁作用,反而会成为污染源。为了避免细菌的滋生和繁殖,毛巾每次使用后最好立即清洗干净并晾晒,有条件的可选择烘干。

定期消毒
常规情况下,使用频次较高的毛巾,应7-10天消毒一次。特殊时期,请增加消毒次数。

※消毒时可放置在微波炉专用保鲜盒中,微波炉大火加热3-5分钟,可在沸水中煮5min,或使用无氯消毒液按照使用说明进行消毒,消毒结束后取出晾干。
※患者使用的毛巾应浸没于装有含氯消毒剂溶液的容器内,加盖。对细菌繁殖体污染的毛巾,使用含有效氯500mg/L的消毒液浸泡不少于10min,对经血传播病原体、分歧杆菌、细菌芽孢污染毛巾的消毒,用含有效氯2000mg/L-5000mg/L消毒液,浸泡不少于30min。
定期换新
用久了的毛巾又脏又硬,滋生的细菌不易杀灭,会成为新的污染源,严重影响健康和使用舒适度。建议面巾、方巾的使用应该在2-3个月左右就要更换一次。
附件:
团体标准 T/HOMETEX4-2018
《毛巾健康使用指南》





(作者:刘雁雁,单位:全国家纺标准化技术委会会毛巾分技术委员会秘书处单位、山东滨州亚光毛巾有限公司)
(封面及内文图来源©摄图网)
[编辑:姝臻]
网址:毛巾健康使用您做对了么? https://www.yuejiaxmz.com/news/view/1056902
相关内容
家居学问大丨错误使用毛巾也会危害健康生活小常识:毛巾变硬怎么办 毛巾的使用保养
毛巾的使用、保存与保养方法
健康锦囊365|“手”护健康,您做对了吗?
毛巾用久了为什么会变黑?简单的小技巧帮助你处理变黑的毛巾
速干毛巾怎么用
毛巾硬了变软妙招
毛巾酒店消毒应该怎么做?
亚发消毒毛巾怎么样 消毒毛巾选购技巧
冬季家庭必备:艾芬达电热毛巾架为您与家人的健康保驾护航

